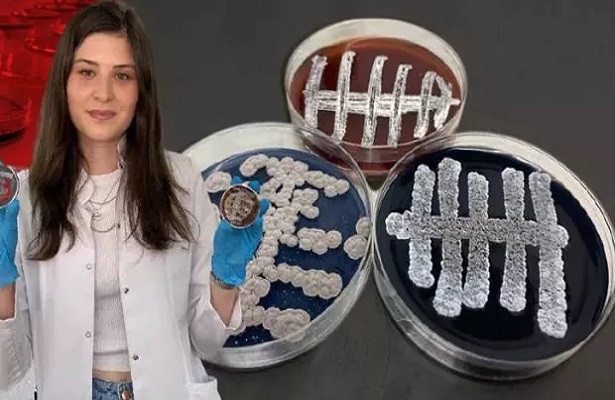

Samsun Ondokuz Mayıs Üniversitesi (OMÜ) Fen-Edebiyat Fakültesi Moleküler Biyoloji ve Genetik Bölümü Başkanı Prof. Dr. Nevzat Şahin ve ekibi, 60 yeni tür bakteri keşfetti.

Fen-Edebiyat Fakültesi Moleküler Biyoloji ve Genetik Bölümü Başkanı Prof. Dr. Şahin ve ekibi, Türkiye, Türkmenistan, Kıbrıs, Rusya, Nijerya ve Hindistan toprakları ile göllerinden aldıkları örnekler üzerinde yaptıkları çalışmaların ardından 60 yeni tür bakteri keşfetti. 2 yıllık çalışma sonucu bulunan türlerin isimlendirilip tanımlandıktan sonra literatüre girmesi bekleniyor.
Keşfedilen bakteri türlerinin, yeni ilaç ve antibiyotik keşfi için de önemli adım olduğunu söyleyen Prof. Dr. Şahin, Türkiye’nin gen kaynaklarından katma değer oluşturma gayreti içinde olduklarını kaydetti. Şahin, “OMÜ olarak moleküler biyoloji ve genetik bölümü laboratuvarlarının altyapısı, uluslararası düzeydedir; önemli bir donanıma sahibiz. Bu alanda OMÜ, Türkiye’nin de öncü üniversitesi, diyebiliriz. Üzerinde çalıştığımız organizmalar daha çok aktinobakteri grubu organizmalarıdır. Aktinobakterler, tedavilerde yaygın olarak kullandığımız yüzlerce antibiyotiğin de elde edildiği mikroorganizmalardır. Dolayısıyla biyoteknolojik önemleri çok fazladır. Keşfettiğimiz organizmaları, doğal habitatları olan toprak, sediment, su, bitki, doku, kök kısımlarından izolasyonlarını yapıyoruz. İzole ettiğimiz organizmaları, uluslararası standartlardaki testlere tabi tutarak tanımlıyoruz. Tanımladığımız mikroorganizmalar içinde yeni türler varsa, bunlara yine uluslararası isimlendirme kurallarına uygun olarak isim veriyoruz. Çok saygın dergilerde makalelerini yayınlayıp, bu türleri literatüre kazandırıyoruz” diye konuştu.
‘ANTİBİYOTİĞİN KAYNAĞI OLMA ÖZELLİĞİNE SAHİP’
Son 10 yılda ekibiyle birlikte 70’ten fazla bakteri türünü literatüre kazandırdıklarını belirten Şahin, “Mikrobiyal gen kaynaklarının tespitine yönelik çalışmalarımız devam ediyor. Son 2 yılda da 60 yeni bakteri türünü keşfettik. Bu bakteri türlerinin büyük bir çoğunluğu genetik özellikleri bakımından antibiyotiğin kaynağı olma özelliğine sahiptir. Bunlarla ilgili yeni ilaç ve antibiyotik keşiflerine yönelik çalışmalarımız da var. Yeni ilaç keşfine yönelik çalışmamızı devlet destekledi. Son 1 yıldır bununla ilgili önemli bulgularla ilerleyen bir çalışmamız daha var. Ayrıca bizim tanımlayarak, ismini verdiğimiz organizmalarla ilgili yeni ilaçların keşfine yönelik çalışma yapan başka gruplar da var. Ülkemizin gen kaynaklarından katma değer oluşturma gayretlerimiz devam edecek” dedi.
KAYNAK: Haber7.com